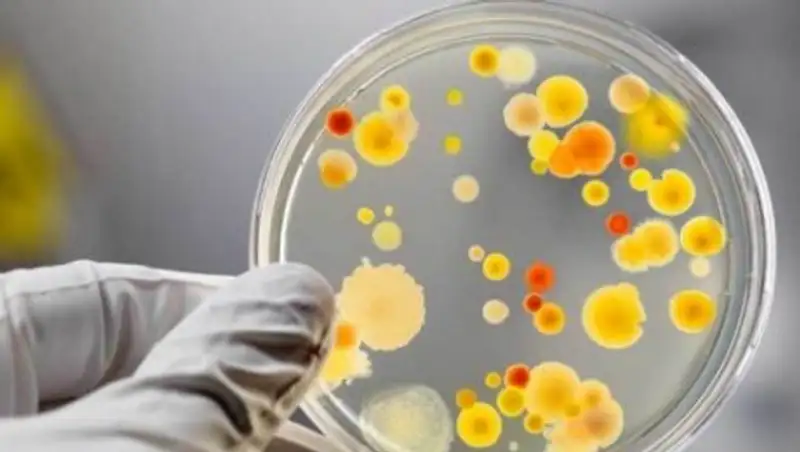

Названа причина массового отравления мороженым в Шымкенте
likar.info
likar.info
Казахстанских реализаторов мягкого мороженого ждет проверка.
В Шымкенте 97 пациентов, жаловавшихся на отравление некачественным мороженым, выписаны из больницы, передает корреспондент МИА «Казинформ».
«На сегодня уже идет выписка пострадавших. В больницах остается 88 человек. 97 уже выписаны. Я думаю, что в ближайшие 1-2 дня все больные будут выписаны», - сообщил в кулуарах СЦК главный санитарный врач страны Жандарбек Бекшин.
Также он озвучил результаты лабораторных исследований.
«Причиной стало заражение продукции возбудителями сальмонеллеза и в незначительной степени стафилококка. Это уже установлено точно», - уверенно заявил главный санитарный врач страны.
Ранее Жандарбек Бекшин сказал, что казахстанских реализаторов мягкого мороженого ждет проверка.
Напомним, порядка 200 человек в Шымкенте предположительно отравились мягким фруктовым мороженым. Ранее в Минздраве сообщали о том, что ведомством ситуация взята под контроль.
Позже больницу посетил аким ЮКО Жансеит Туймебаев. Он поручил руководителю ответственного управления привлечь дополнительно врачей-специалистов и создать все необходимые условия для пациентов.
Азамат Сыздыкбаев
Поделитесь новостью
Читайте также
Если вы видите данное сообщение, значит возникли проблемы с работой системы комментариев. Возможно у вас отключен JavaScript












